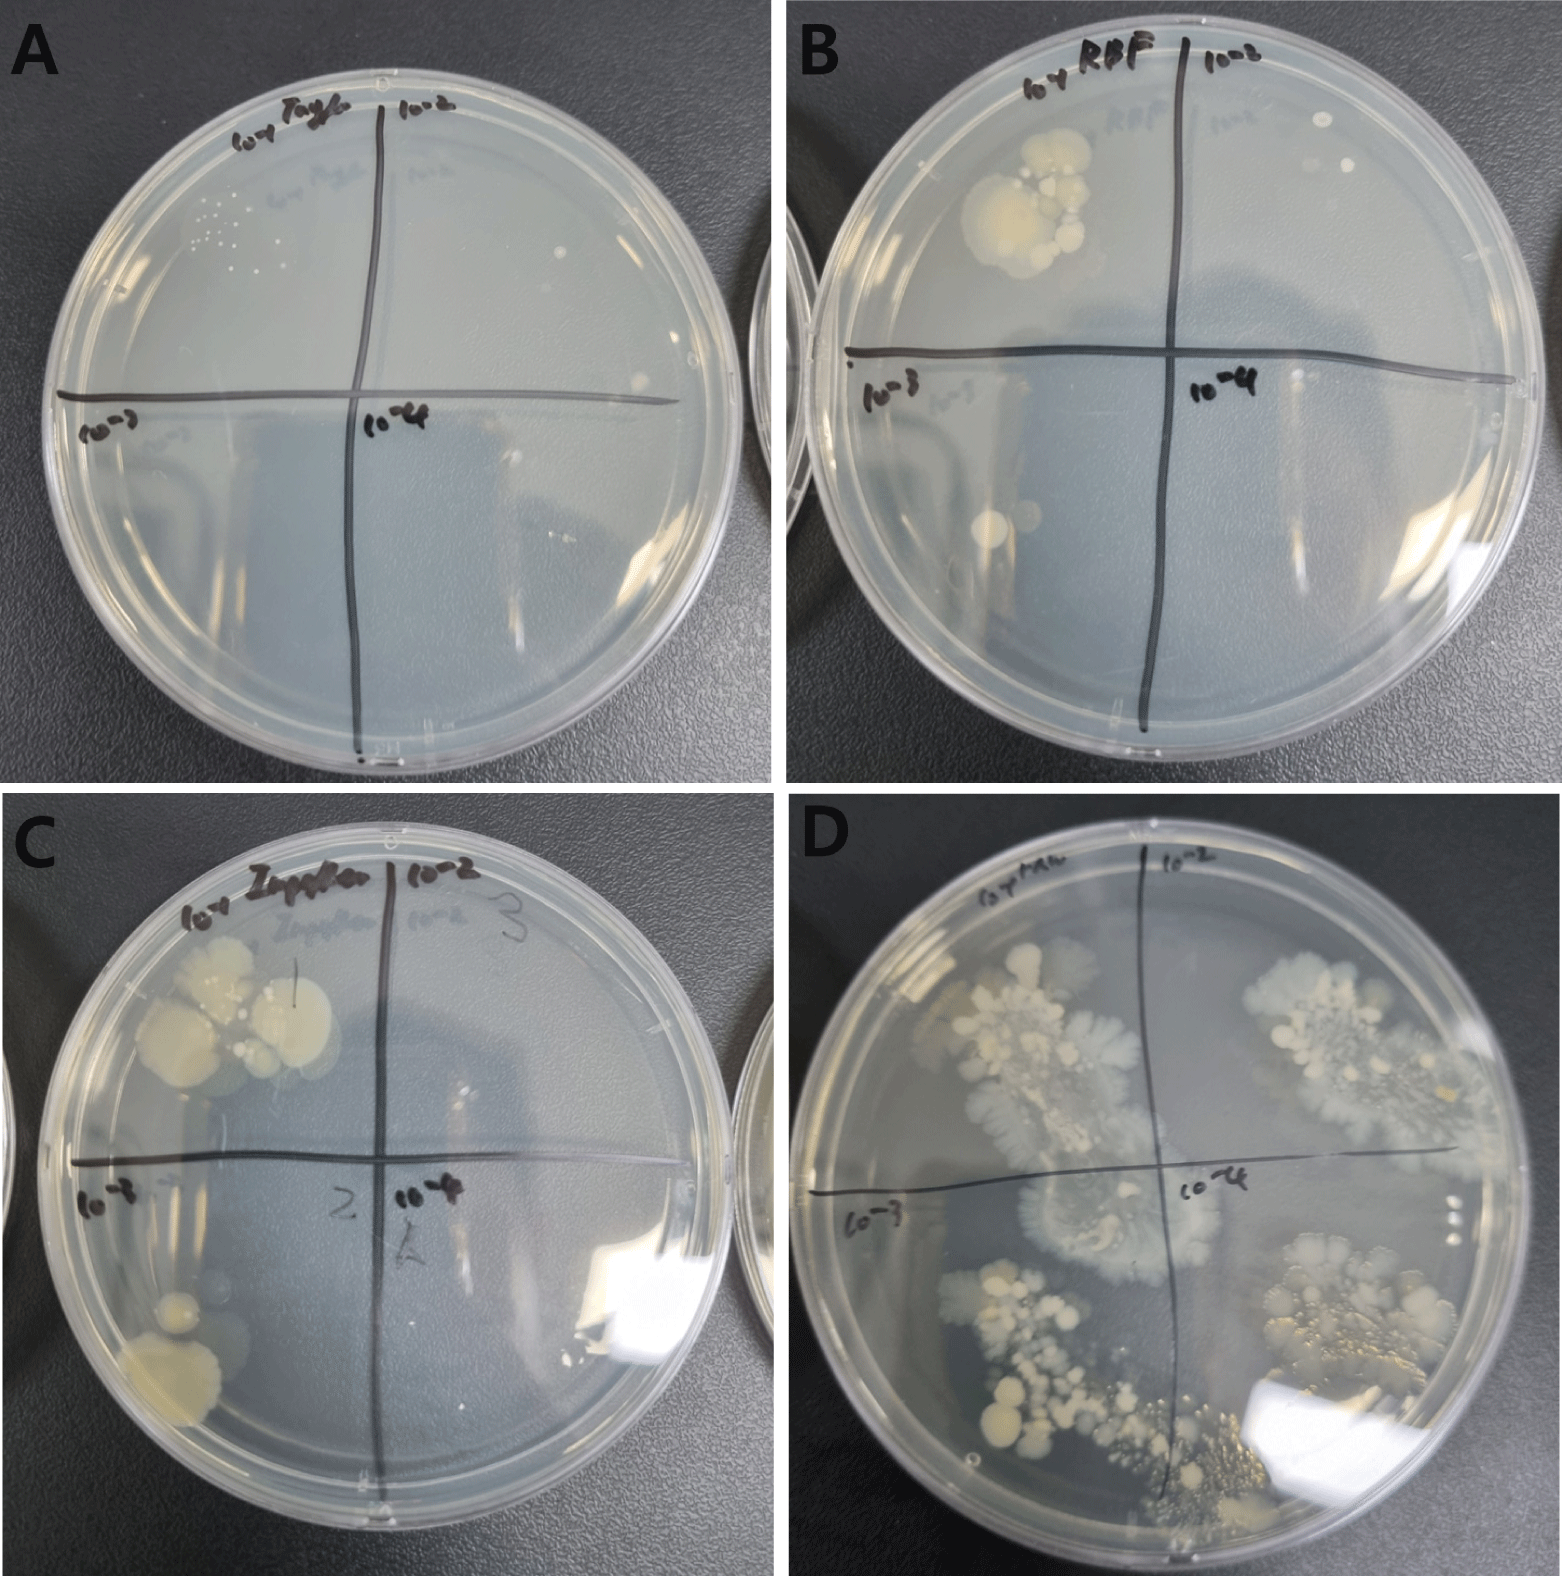
fep-29-4-310-g6

서 론
원유는 유가공 산업에서 식품 원료로 사용되고 있지만, 다양한 미생물을 포함하고 있어 식품 안전성과 품질 관리에 있어 살균은 매우 중요하게 여겨지고 있다(Li et al., 2018; Scholz-Ahrens et al., 2020). 원유 내 미생물은 부패를 유발하거나 병원성 문제를 일으킬 수 있으며, 이는 유제품의 저장 기간과 소비자 건강에 직접적인 영향을 미친다(Barbano et al., 2005; Séverin et al., 2005; László et al., 2018; Deeth, 2020). 이러한 이유로 원유의 살균은 필수적인 공정으로 자리 잡았으며, 특히 가열을 통한 저온 살균은 원유의 신선도와 영양소를 최대한 보존하면서 미생물을 제거하는 데 초점을 맞추어 발전 및 변화가 있었다(Lamberti et al., 2018; Khayrullin et al., 2023). 이때 사용되는 우유 및 기타 액상식품의 살균에는 일반적으로 LTLT (low temperature long time) 및 HTST (high temperature short time) 공정이 널리 사용된다. LTLT 공정은 약 63℃에서 30분간 유지하는 저온 장시간 살균 방식으로, 비교적 낮은 온도에서 오랜 시간 처리함으로써 단백질 변성이나 풍미 손실이 적고 품질 유지에 유리하다. 그러나 긴 처리 시간과 낮은 에너지 효율로 인해 대량 생산에는 부적합하다는 한계가 있다. 또한 HTST 공정은 약 72℃에서 15초간 유지하는 고온 단시간 살균 방식으로, 미생물을 효과적으로 사멸시키면서도 영양소 손실이 최소화된다는 장점을 지닌다(Tamime, 2009; Liu et al., 2020). 추가적으로 초음파 및 자외선을 이용한 살균 방식 또한 식품산업에서 보고되고 있다(Cameron et al., 2009; Orlowska et al., 2014; Elçiçek & Güzel, 2020). 또한 살균 방식의 발전에 맞춰서 원유 품질 및 박테리아의 분석 방법도 새롭게 고안되고 있다(Lu et al., 2013; Júnior et al., 2018; Kamil et al., 2021). 그러나 기존의 저온 살균 방법, 예를 들어 임펠러를 활용한 공정은 여러 한계를 드러내고 있다. 교반에서 높은 열효율과 물질전달 효율을 가지는 테일러 와류 혼합기와 달리, 위 방법은 낮은 열전달 효율과 불균일한 유체 혼합으로 인해 긴 처리 시간이 필요하며, 원유의 산패(酸敗)를 가속화하고 품질 저하를 초래할 수 있다(Masuda et al., 2017). 또한, 연속식으로 살균이 진행되는 것에 어려움으로 인해 배치식으로(batch system) 살균이 진행됨으로, 시간당 살균 효율이 비교적 낮기 때문에 대량 처리 시 경제적 부담을 가중시킨다. 이러한 문제들은 식품 공학 분야에서 보다 효율적이고 지속 가능한 살균 기술 개발의 필요성을 부각시키고 있다.
따라서 테일러 와류 반응기를 이용한 원유의 살균을 고안하게 되었다. 테일러 와류란, 두 동심 원통 사이에서 발생하는 규칙적인 와류 흐름으로 내부 원통만 회전시켜 얻을 수 있다. 이러한 테일러 와류 흐름은 유체의 혼합 효율과 물질 전달 성능을 극대화시켜 결정화 및 콜로이드 입자의 합성 분야에 적용되어 왔다(Nguyen et al., 2024; Chung et al., 2025). 이 흐름의 균일한 교반 성능과 유체 흐름을 통해 열전달 효율을 높이고, 반응 속도를 개선하며 물진 전달 효율를 높여 균일한 입도를 갖는 나노 입자의 합성에도 사용되어 왔다(Nguyen et al., 2024; Chung et al., 2025).
하지만 식품 공학, 특히 원유 살균 분야에 테일러 와류를 적용한 연구는 아직 초기 단계에 머물러 있다. 원유는 단백질, 지방, 탄수화물 등 복잡한 성분으로 구성된 생물학적 콜로이드로, 일반적인 화학 물질들과는 다른 특성을 보이며, 이에 따라 살균 과정에서 품질 유지와 미생물 제거라는 두 가지 목표를 동시에 충족시키는 것이 중요하다.
기존 연구들은 주로 비식품 공정에 초점을 맞춰 왔기 때문에, 원유와 같은 식품 콜로이드(food colloids)에서 테일러 와류의 적용 가능성과 그 효과를 체계적으로 검증한 사례는 제한적이다. 하지만 점도가 높은 전단 담화(shear-thinning) 유체를 모델로 사용하여 테일러 와류 혼합기 내에서 유체의 열전달 특성을 확인하여 액상 식품에의 적용 가능성을 수치 해석적으로 확인한 기존 문헌은 보고된 바 있다(Masuda et al., 2017). 본 연구에서는 테일러 와류를 원유의 살균에 실제로 적용하여 원유의 저온 살균 기술을 개발하고, 기존의 임펠러에 기반한 방식과 비교하여 살균 효율 및 품질 보존 측면에서 그 우수성을 평가하고자 하였다. 원유의 미생물 제거 효율을 극대화하고, 산패와 같은 품질 저하 요인을 최소화하는 새로운 공정 방식을 제안함으로써 식품 안전성과 유가공 산업의 지속 가능성을 높이는 데 기여하고자 한다.
재료 및 방법
본 연구에 사용된 원유는 충청남도 천안시에 위치하고 있는 효덕 목장에서 살균 전 원유를 공급받아 사용하였으며, 착유 직후 실험실로 이동하여 즉시 측정과 살균 실험을 개시하였다. 본 연구에서는 원유의 저온 살균 공정의 효율성을 비교하기 위해 세 가지 형태의 혼합기를 사용하였다. 실험에 사용된 혼합기는 각각 반달 모양의 임펠러를 장착한 둥근 바닥 플라스크, 마그네틱 바를 이용한 둥근 바닥 플라스크, 그리고 테일러 와류 혼합기였다. 이때 사용된 둥근 바닥 플라스크는 모두 100 mL의 부피를 갖는 초자를 사용하였다. 임펠러를 활용한 살균 실험의 경우 반달모양의 임펠러와 둥근 바닥 플라스크의 바닥 사이에 교반을 위한 5 mm의 틈을 유지하였다. 테일러 와류 혼합기는 ㈜라미나에서 제작된 LCTR-mini-H 모델이 사용되었으며, 내부 및 외부 실린더의 치수와 높이는 Table 1과 같다.
| Diameter or length (mm) | |
|---|---|
| Radius of inner cylinder (r1) | 20 |
| Radius of outer cylinder (r2) | 35 |
| Height of cylinders (L) | 45 |
모든 혼합기에는 동일하게 25 mL의 원유를 주입하였으며, 실험 전 원유는 4℃에서 보관하면서 실험 직전 상온에 꺼내어 온도 평형을 맞춘 후 사용하였다. 살균 실험은 기본 조건으로 500 rpm으로 작동하는 혼합기에서 63℃, 30분의 조건으로 수행하였으며, 이후 두 가지 변수를 설정하여 살균 조건을 변화시켰다. 첫 번째로, 시간에 따른 살균 효과를 평가하기 위해 63℃를 유지한 상태에서 각각 10, 20, 30, 40분 동안 살균을 진행하였다. 두 번째로, 온도에 따른 영향을 확인하기 위해 살균 시간을 30분으로 고정하고, 가열 온도를 55, 63, 70, 75℃로 변화시켜 실험을 수행하였다. 온도 조절은 테일러 와류 혼합기의 경우 워터 재킷을 이용하였으며, 그 외 혼합기에서는 물을 활용한 중탕으로 유지하였으며, 각 혼합기는 온도에 도달한 후 설정된 시간만큼 유지되었다.
연속식 원유 살균에는 E.M.S Tech사의 EMP-100A 모델과 Masterflex사의 96410-13 튜브를 이용하여 원유의 공급 및 토출을 수행하였으며, 모든 유량과 속도를 정밀하게 조절하였다. 기존 살균과 같이 연속식 살균에서도 임펠러, 마그네틱 바, 테일러 와류 혼합기가 사용되었으며, 이때 총 용량 25 mL를 기준으로 머무름 시간을 10, 20, 30, 40분으로 변화를 관찰하고자 펌프의 속도를 2.5, 1.25, 0.833, 0.625 mL/min으로 조절하여 실험을 진행하였다. 또한 모든 연속식 살균 샘플들은 3번에 걸친 프리런(pre-run)을 통한 플러싱(flushing)을 통하여 연속식을 진행하였을 때의 오차를 줄이고자 하였다. 자외선(UV light)를 이용하여 추가적인 살균을 진행하기 위해 테일러 와류 혼합기가 500 rpm, 63℃의 조건에서 사용되었으며 자외선 발생장치(UV 램프)는 SANKYO DENKI사의 Blacklight Blue 모델 7개가 사용되었다.
샘플들은 온도가 유지되는 상온(24℃) 또는 냉장(4℃)에서 보관되었으며, 상온 샘플의 경우 7일간, 냉장 샘플의 경우 21일 동안 관찰되었다. 이때 살균이 끝난 원유샘플들은 살균 처리된 15 mL 코니칼 튜브에서 보관되었으며, 상온샘플의 경우 항온으로 유지되는 독립적인 공간 속 후드에서 보관되었으며, 냉장샘플의 경우 4℃로 온도가 일정하게 유지되는 냉장실에서 보관되었다. 살균 처리 후 산-염기 적정법을 이용하여 미생물의 대식 활동을 통해 생성된 젖산에 의한 산패도를 측정하였다(O’Connor, 1995). Sodium hydroxide (1 N, 대정화금)을 0.01 N로 희석하여 사용되었으며, 지시약으로는 페놀프탈레인 1 g을 에탄올(99.8%, 대정화금) 100 mL에 용해하여 사용하였다. 적정에는 DI water 1 mL, 샘플 1 mL, 페놀프탈레인 지시약 0.02 mL를 투입한 뒤 지속적으로 흔들면서 sodium hydroxide 수용액을 투입하여 연한 분홍색이 도달하였을 때 이를 종말점으로 간주하고 산-염기적정을 마무리하였다.
본문에서 °SH (Soxhlet-Henkel degree)는 산도(acidity)를 나타내는 지표로 사용되었으며, 일반적으로 100 mL 원유를 중화하는 데 필요한 0.25N NaOH 수용액의 부피(mL)를 의미한다. 미생물의 대사과정에서 젖산(lactic acid)이 생성되기 때문에, 이 수치는 원유의 부패 정도를 간접적으로 나타낸다. 또한 대한민국 식품공전에서는 산도(%) 0.18 이하는 유통가능한 우유의 기준으로 정해져 있다. 본 연구에서는 °SH를 사용하였으며, 산도(%)와 °SH와의 관계식을 아래와 같다.
Acidity (% lactic acid) = (VNaOH × NNaOH × 0.09) / Vmilk
Acidity (% lactic acid) = °SH × (0.25 × 0.09) / 100 = °SH × 0.00225
이때 VNaOH는 NaOH 수용액의 투입 부피(mL), NNaOH은 NaOH의 농도이며 위 실험에서는 0.01N가 사용되었다. Vmilk는 실험에 사용된 원유 샘플의 부피(mL)이며, 통상적으로 1 mL가 사용되었다. 0.09는 젖산의 밀리당량 무게(90 g/eq ÷ 1,000 = 0.09 g/mEq)를 나타내며, 이를 통해서 식품공전에서 제시하는 산도(%)와 비교가 가능하다. 같은 샘플의 °SH와 산도(%)의 비교는 Table 2에 나타내었다.
살균을 통해 잔존하는 미생물들을 확인하기 위하여 배지(culture medium)를 제작하고, 살균된 원유를 희석하여 도말 후 관찰하였다. 각 조건에 따라서 샘플이 3개씩 제작되었으며, 이때 사용된 배지는 Difco™사의 PCA (Plate Count Agar)가 사용되었다. 23.5 g을 1 L에 용해 후 섭씨 121.5℃에서 15분간 작동된 오토클레이브에서 살균을 진행하였으며, 각 샘플마다 20 mL씩 나눠 무균 작업대(clean bench)에서 굳힌 뒤 사용하였다. 원유 희석은 10–1, 10,–2 10–3, 10–4 배율로 진행되었으며, HIMEDIA사에서 공급되는 Phosphate Buffered Saline (PBS) (Ph.7.4)을 이용하여 희석하였다. 만들어진 배지 위에 희석된 원유를 0.02 mL씩 떨어뜨린 뒤, 35℃로 온도가 유지되는 인큐베이터에서 48시간 이후 잔존하는 미생물들을 확인하였다. 위와 같은 방법을 통해 각 반응기의 살균 효율과 품질 보존 능력을 종합적으로 평가하였다. 배양된 미생물이 존재하는 영역의 넓이를 측정하기 위해서 TEAM INKSCAPE사의 inscape가 이용되었으며, 반응기에 따라서 제작된 샘플 3개의 면적을 측정하고, 평균값을 얻은 후 살균되지 않은 원유 샘플을 100%로 설정하여 백분율(%)로 나타내어 그에 따른 살균효과를 확인하였다.
결과 및 고찰
본 연구에서는 산패도를 미생물 대사 활성의 지표로 활용하였다. 일반적으로 산패도는 미생물의 성장과 젖산 생성에 따라 증가하므로, 낮은 산패도는 미생물의 활성이 억제되어 있음을 의미한다. 따라서 살균 공정을 통해 산패도가 낮게 유지된 경우, 이는 미생물 사멸이 효과적으로 이루어졌음을 나타내는 지표로 해석될 수 있다. 본 연구 결과에서도 산패도가 낮게 유지된 시료에서 살균 효과가 우수하게 나타났으며, 이는 살균 후 미생물의 생존 및 대사 활동이 제한되었기 때문으로 판단된다. Fig. 1과 같이 테일러 와류 혼합기와 기존 둥근 바닥 플라스크 기반의 두 방식들(임펠러 교반형, 마그네틱 바 교반형)을 이용하여 원유의 저온 살균 실험을 수행하고, 각각의 반응 조건에서 살균 효율과 품질 보존 정도를 비교하였다. 실험은 63℃에서의 기본 조건(30분간 살균)을 위주로, 시간(10, 20, 30, 40분) 및 온도(55, 63, 70, 75℃) 변수에 따른 살균 효과와 산패 경향을 분석하였다. 63℃에서의 살균 시간 변화에 따른 미생물 수 감소와 산패도(pH, 산도)를 비교한 결과, Fig. 2A에서 볼 수 있듯이 상온 샘플에서 세 혼합 시스템 모두 살균 시간이 증가함에 따라 미생물 수가 점진적으로 감소하였으며, 젖산의 생성양도 억제되어 산패도가 낮아지는 경향을 보였다. 특히 테일러 와류 혼합기를 활용한 경우 10분 처리 시점에서 이미 임펠러형 혼합기의 30분 가열 결과에 상응하는 수준의 살균 효과를 확인하였다. 이에 비해 마그네틱 바를 활용한 혼합기는 교반력의 한계로 인해 살균 성능이 낮았고, 동일 조건에서도 잔존 미생물이 높은 수준으로 확인되었다. Fig. 2B에 나타낸 것처럼 살균 온도를 30분간 고정하고 55℃부터 75℃까지 변화시켜 비교한 결과, 가열 온도가 상승할수록 세 혼합기 모두 미생물 제거율이 향상됨을 확인하였다. 특히 63℃ 이상에서 살균 효과의 향상이 나타났으나, 일부 고온 조건에서는 산패도 지표인 젖산 생성양이 오히려 증가하거나, pH 감소 폭이 커지는 등 품질 저하의 징후가 관찰되었다. 이는 고온에 의한 단백질 변성과 지질 산화 반응이 촉진된 결과로 해석될 수 있다. 특히 혼합기에 관계없이 55℃에서 살균된 샘플을 산패가 매우 빠르게 진행되었으며, 살균 효과가 미미한 것으로 여겨진다.


테일러 와류 혼합기의 경우, 63℃와 70℃에서 모두 균일한 살균 성능을 보였으며, 품질 변화 또한 가장 안정적인 수치를 기록하였다. 이는 혼합기 내부 유체의 흐름에 규칙적인 와류 구조가 형성되어 열과 물질의 전달을 효과적으로 증진시켰기 때문으로 판단된다. 이에 반해 기존 혼합기에서는 특정 온도 구간에서 살균 불균형이나 품질 편차가 크게 나타났으며, 특히 마그네틱 바를 활용한 시스템에서는 70℃에서도 일정 수준의 미생물 생존이 확인되었다. 또한 Fig. 2B에 삽입된 사진과 같이 부패가 모두 진행되면 우유의 지방은 위로 떠오르고 산에 의해 단백질은 가라앉으며, 유청은 중간부분에 있는 모습을 확인할 수 있었다.
Fig. 3A에는 냉장 보관 샘플의 산도 적정 결과를 통한 젖산 축적양을 간접적으로 나타내었다. 살균 시간에 따른 산-염기 변화로부터 살균 시간이 짧을 때 살균효과가 불충분하여 산도가 빠르게 상승하는 경향을 확인하였고, 모든 형태의 혼합기로부터 10분에서 급격히 산도가 올라가는 모습을 확인하였다. 또한 Fig. 3B에서 확인할 수 있듯이 온도가 낮은 조건에서는 젖산 생성량이 비교적 많았으며, 이는 살균 미비로 인해 유산균의 증식이 지속되었음을 시사한다. 특히 55℃에서 살균을 진행하였을 때는 살균 효과가 매우 떨어지는 경향이 모든 혼합기에서 나타났다. 테일러 혼합기에서는 63℃ 및 30분의 처리 조건에서 이미 pH 안정성과 낮은 산도 수치를 기록하였고, 저장 기간 중 산패 현상도 상대적으로 느리게 진행되었다. 위와 같은 결과를 나타낸 반응기별 에너지 효율을 분석하기위해 위실험들의 에너지 소비량의 추정치를 계산해 보았다. 동일한 실험 조건(초기 온도 20℃의 물 2 L를 63℃까지 가열 후 30분간 유지, 교반 속도 500 rpm) 하에서 살균이 물 중탕을 사용한다고 가정하였을 때 각 장치 조합의 전력 소모량을 산출하였다. 모든 계산은 다음과 같은 기본 열에너지식을 기반으로 하였다.

여기서, m은 물의 질량(2 kg), c는 비열(4,186 J·kg–1·℃–1), ΔT는 온도 변화(43℃)이다. 이때 필요한 열에너지는 359,998 J로, 1 kWh = 3.6 × 106 J임을 고려하면 약 0.100 kWh의 이론적 에너지가 필요하다. 히터의 효율을 90%로 가정할 경우 실제 전기 에너지는 0.100 / 0.9 = 0.111 kWh로 산정하였다. 가열 완료 후 30분간 유지 단계에서는 열 손실 보상을 위해 히터 정격 출력의 약 40%가 평균적으로 소비된다고 가정하였다.
사용된 교반핫플레이트 매뉴얼에 따르면 S72525의 정격 소비전력은 18.8 W이다. 본 장치는 별도의 외부 히터 없이 내부 발열부로 가열이 이루어진다고 가정하였다. 필요한 가열 에너지가 0.111 kWh임을 고려할 때, 가열 시간은
으로 계산되며, 이후 30 분간의 유지 단계를 포함하면 총 운전 시간은 약 6.41 h이다. 이에 따른 전체 소비 전력은
으로 산출되었다. 단, 계산적으로는 6시간 이상이 소요되어 실제 실험 운영에는 비현실적인 수준임을 확인하였다.
중탕식 가열기 모델 RI-DF100와 임펠러 교반기 모델 MS5010D를 사용한 경우에는, 320 W 히터를 이용하여 물 2 L를 63℃까지 가열할 때, 효율 90% 기준 전기 소모량은 0.111 kWh이며, 가열 시간은 다음과 같다.
가열 완료 후 30분 유지 시 히터의 평균 소비 전력은 40% 부하(128 W)로 가정하면, 유지단계 소비량은 128 W × 0.5 h = 0.064 kWh이다. 임펠러 교반기(120 W)는 전 과정(0.847 h) 동안 동작하므로, 교반 에너지는 120 W × 0.847 h = 0.102 kWh이다. 따라서 전체 소비전력은
으로 계산된다.
테일러 와류 믹서와 서큘레이터 모델 CW-05G를 함께 사용한 경우는 CW-05G의 순환수조에 4 L의 물을 가열하는 조건에서 이론적 열에너지는 0.200 kWh, 효율 90%를 적용하면 실제 전기 소모량은 0.222 kWh이다. 1000 W 히터 사용 시 가열 시간은
이다. 유지단계에서는 히터 평균 40% 부하로 0.2 kWh가 추가로 소비된다. 테일러 와류 믹서의 모터(500 W)와 CW-05G의 펌프(100 W)는 전체 운전시간(0.722 h) 동안 작동한다고 가정하면 각각 0.361 kWh와 0.072 kWh를 소모한다. 따라서 총 소비전력은 아래와 같다.
에너지 소비량의 결과를 종합하면, 교반 핫플레이트(S7252)는 전력 소모 자체는 가장 적지만(0.121 kWh) 가열 시간이 과도하게 길어 실험 효율이 떨어진다. 반면 중탕식 가열기와 임펠러 교반기 조합은 0.277 kWh로 비교적 낮은 소비전력 대비 짧은 가열 시간을 확보하여 효율적이다. Taylor reactor+CW-05G 시스템은 4 L의 순환 가열 및 500 W 모터 부하로 인해 0.855 kWh로 가장 높은 전력 소모를 보였으나, 대용량 처리 및 균일한 열·물질전달 성능을 제공한다는 점에서 연속식 살균 및 지속적인 작동 조건하에서는 에너지 소비 증가를 상쇄할 만한 실험적 이점을 가진다. 하지만 위 계산들은 추정치임으로 실제로 실험에서 사용된 소비전력을 알기는 힘들다는 한계가 존재한다.
연속식으로 원유 살균을 진행하였을 때의 살균 시간과 혼합기별 산패도를 확인하였다. 상온 보관에서 샘플들의 산-염기 적정결과는 Fig. 4A에 나타낸 것처럼 3일 차에서 급격하게 산패가 진행되는 것을 확인하였으며, 테일러 와류 혼합기를 이용한 샘플들이 모두 마그네틱 바와 임펠러를 사용하여 살균한 샘플에 비해 산패가 비교적 천천히 진행되었음을 알 수 있다. Fig. 4B에서 확인할 수 있듯이 냉장 보관 샘플에서도 유사한 경향이 나타났으며, 13일 차부터 급격한 산패가 진행되었다. 냉장 샘플에서도 임펠러를 이용하여 살균한 샘플의 산패가 가장 빨랐으며, 마그네틱 바, 테일러 와류를 사용하여 살균된 샘플의 산패 속도가 그 뒤를 이었다. 냉장 샘플의 경우 혼합기별 산패도는 큰 차이를 보이지 않았지만, 테일러 와류 혼합기를 이용하여 살균한 샘플의 경우는 살균력의 차이가 크게 나타났다. Fig. 5A에서 확인할 수 있듯이 연속식 샘플과 회분식 샘플의 살균 결과가 현저한 차이를 보임을 알 수 있다. 이는 연속식 살균이 지속적으로 원유 유입을 통해 대량의 시료를 처리할 수 있는 장점이 있지만, 살균력 자체는 같은 조건으로 진행하였을 때 회분식 살균 방식에 비해 떨어진다는 단점을 확인할 수 있다. 이러한 결과는 냉장 샘플인 Fig. 5B에서도 확인할 수 있다. 하지만 냉장 샘플의 결과에서는 그 차이가 극명하게 나타나지 않았다.


테일러 와류 혼합기에 자외선을 조사하는 경우, 추가적인 살균 효과를 확인하기 위하여 테일러 와류를 활용한 회분식 및 연속식 실험의 샘플, 자외선 조사의 회분식 실험 샘플, 자외선 조사에 의한 연속식 실험 샘플의 시료를 각각 확보하였다. 보관 기간에 따른 산패도를 확인하기 위하여 산-염기 적정을 진행하였으며, Fig. 5A와 같이 상온에서 보관한 테일러 와류 샘플들의 산패도를 확인할 수 있었다. 자외선 조사의 효과가 크게 나타나지는 않았으나, 연속식 실험의 경우 상대적으로 수준에서나마 자외선 살균의 효과를 확인할 수 있었다. 우유는 불투명한 콜로이드 용액으로써 자외선과 같은 빛을 산란시켜 투과도를 떨어뜨리기 때문에 현저한 살균효과를 기대하기는 어려운 것으로 판단된다. 하지만 냉장 보관 샘플들의 산패도 그래프인 Fig. 5B에서 확인할 수 있듯이, 연속식 실험에서의 자외선 조사의 효과가 비교적 두드러지게 측정되었다. 이는 연속식으로 실험을 진행할 때 원유의 유입/유출구와 같은 추가적인 유체의 흐름에 자외선이 조사되어 나타난 결과로 해석된다(Orlowska et al., 2014).
Fig. 6의 결과와 같이 48시간 동안 배양한 각 살균 공정의 원유 시료를 도말한 배지를 관찰한 결과, 각각의 가열 방식별로 미생물의 생존 양상과 증식 정도에서 뚜렷한 차이를 확인할 수 있었다. 이때 비교된 서로 다른 샘플들의 희석배수는 10–1배이다. Fig. 6A에 나타낸 테일러 와류 혼합기로 살균한 시료에서는 전반적으로 콜로니 수가 많아 보일 수는 있으나, 각 콜로니는 매우 작고 서로 간의 간격이 넓어, 개별적으로 분리된 형태로 배양되었다. 이러한 특성은 테일러 와류 혼합기에서 발생하는 규칙적인 와류들에 의해 원유 전체에 고르게 교반과 열전달을 유도함으로써 대부분의 미생물들이 효과적으로 사멸되고, 일부 생존한 세포들도 증식 활성이 낮은 상태로 남았기 때문으로 해석된다. 즉, 개별 콜로니의 크기가 작고, 퍼짐 없이 국한된 영역에 분포되어 있다는 점은 잔존 미생물의 생장력이 억제되어 있었음을 시사한다(Breakwell et al., 2007). 따라서 콜로니 수가 다소 많은 듯 보여도 그 크기와 밀도, 형태를 종합적으로 고려할 때, 테일러 와류 혼합기의 살균 효과는 우수한 것으로 해석된다. 반면, Fig. 6B와 같이 마그네틱 바를 사용한 방식에서는 콜로니 수 자체가 많지는 않았지만, 개별 콜로니들이 넓게 퍼져 있고, 덩어리처럼 융합된 형태가 빈번하게 관찰되었다. 이는 열 에너지가 원유 전반에 고르게 전달되지 못해 일부 미생물들이 살균을 회피하고 생존하였으며, 이후 빠른 속도로 증식하였음을 나타내는 결과로 해석될 수 있다. 특히 내부 유동이 상대적으로 정체되는 구간이 존재할 수 있는 RBF (round-bottom flask)의 구조상, 교반만으로는 완전한 균일성을 확보하기 어렵기 때문에 살균 처리의 국부적 편차가 발생했을 가능성이 있다. 이로 인해 도말된 배지에서는 면적으로 확산된 대형 콜로니가 주로 나타나며, 이는 곧 미생물의 생존력과 번식 가능성이 테일러 혼합기에 비해 높았음을 의미한다.
임펠러 기반 혼합기의 경우, Fig. 6C와 같이 교반력이 강하다는 장점에도 불구하고 열전달의 효율이 떨어지는 구조적 한계로 인해 미생물 사멸의 일관성이 확보되지 않았다. 실제 배양 결과에서도 마그네틱 바 교반으로 얻은 샘플보다 더 넓게 퍼진 콜로니들이 관찰되었으며, 이는 살아남은 미생물들이 고농도로 존재하고 있으며, 충분한 환경에서 빠르게 증식했음을 의미한다. 임펠러의 회전력은 강력하지만, 원유에 직접적으로 열이 전달되지 못하는 교반 사각 지대(dead zone)가 발생하면 내부 온도 분포의 균일성을 떨어뜨려 불완전한 살균의 원인이 될 수 있다. 결과적으로, 이 혼합기의 시료에서는 크고 퍼진 콜로니들이 다수 출현하여, 도말된 배지의 시각적 면적 또한 가장 넓게 나타났다.
Fig. 6D의 결과처럼 무처리 원유(raw milk) 시료에서는 전 희석 배율에 걸쳐 과도한 콜로니가 형성되었으며, 특히 다른 샘플들은 성장하지 못한 10⁻4의 희석 배수에서도 다수의 콜로니가 겹쳐진 상태로 관찰되어 콜로니의 넓이가 매우 증가되었다. 따라서 콜로니 간의 경계가 거의 식별되지 않을 만큼 밀집되어 있었으며, 크기도 크고 불규칙적으로 퍼져 있었다. 이는 원유의 착유 직후 살균 개시 직전까지 이송하는 동안에도 미생물의 급속한 번식이 일어나고 있으며, 살균을 거치지 않은 원유는 유통 또는 섭취에 있어 심각한 위생적 위험을 초래할 수 있음을 보여준다. Fig. 7은 위와 같은 다양한 반응기, 살균 조건에 따라서 살균된 샘플을 배양하여 평균면적을 계산하고 표준편차를 막대그래프로 나타낸 그림이다.

같은 종류의 혼합기로부터 얻은 서로 다른 샘플 3개를 각각 10–1배로 희석하여 얻은 부분의 배지로부터 inkscape를 이용하여 측정한 면적의 평균을 얻은 뒤, 무처리 원유의 10–1배로 희석된 샘플의 성장 면적을 100%로 가정하고 다른 샘플들의 면적을 상대적인 백분율로 나타내었다. 그 결과 임펠러를 활용한 가열 샘플은 50.37, 마그네틱 바를 활용한 가열 시료는 29.51%로 측정되었다. 이러한 결과는 같은 형태의 용기에서 교반되었지만 임펠러의 경우 교반의 사각지대가 존재하여 효과적인 물질전달 및 열전달이 이루어지지 않았기 때문으로 해석된다. 테일러 와류 혼합기의 경우 2.03%였으며, 이는 미생물이 존재하지만 더 이상 성장이 불가능하며 살균이 가장 효과적으로 진행되었음을 시사한다. 또한 자외선을 조사한 샘플의 경우 0.47%로, 이는 우유의 탁도가 높아서 자외선을 통한 살균효과는 크게 기대할 수 없지만, 추가적으로 산패를 억제한다는 점을 간접적으로 나타낸다. Fig. 8에는 이러한 결과들을 한눈에 파악할 수 있도록 heat map을 나타내었다.

또한 본 연구의 다양한 혼합기 및 연속식 살균 샘플을 배지에 도말하여 콜로니의 면적을 추가적으로 확인하였다. 이때 희석이 덜 이루어진 10–1 및 10–2배에서는 미생물의 과도한 성장이 진행되었다. 따라서 샘플들을 비교하기 위해 면적을 측정한 서로 다른 연속식 살균 샘플의 희석배수는 10–3배로 설정하였다. 희석된 부분의 면적을 평균값으로 계산하고 무처리 원유의 10–3배 희석된 샘플의 성장면적을 100%로 가정하여 이에 대한 상대적인 백분율로 나타내었을 때, 임펠러와 마그네틱 바를 활용한 경우 각각 56.65 및 56.01%였으며, 마그네틱 바로 교반하며 살균한 샘플이 임펠러로 살균된 샘플에 비해 근소하게 살균이 더 진행된 것으로 판명되었다. 테일러 와류로 살균된 샘플과, 추가적으로 자외선이 조사된 샘플의 경우 37.77 및 34.75%였으며, 이는 기존 살균 방식보다 테일러 와류를 이용한 저온 살균의 효과가 더 우수함을 나타낸다. 자외선을 조사한 경우 미미하지만 살균 효과의 증대가 있다고 판단된다. 이러한 배양 결과를 종합적으로 비교할 때에는 단순히 콜로니 수의 비교만으로는 살균 효율을 정확히 판단하기 어렵고, 콜로니의 크기, 밀도, 형상 등 여러 요인을 고려해야 한다. 특히 테일러 와류 혼합기의 경우, 비록 소수의 작은 콜로니들이 관찰되었으나 미생물의 생장력이 제한된 상태로 존재하였다는 점에서 살균 효율이 가장 우수하고 품질 보존 측면에서도 효과적인 처리 방식임을 입증하였다.
살균 실험 후 샘플을 상온(24℃) 및 냉장(4℃) 보관하여 각각 7, 21일간 품질 변화를 추적한 결과, 테일러 와류 혼합기로부터 살균한 샘플이 산도 변화 및 미생물 재증식에 가장 강한 저항성을 보였으며, 다른 혼합기로부터 얻은 샘플에 비해 보존성이 우수하였다. 특히 테일러 와류 혼합기를 이용한 샘플은 상온 보관 4일 후에도 일반적인 부패가 진행되지 않은 신선한 우유라고 판단되는 °SH 8을 넘지 않았다. 테일러 와류 혼합기 샘플은 산패의 가속화가 가장 적게 나타났고 이는 저장 안정성 측면에서도 가장 유리함을 시사한다.
요 약
본 연구에서는 원유의 저온 살균에 활용된 테일러 와류 혼합기의 결과를 기존의 임펠러 및 마그네틱 바를 활용한 혼합 시스템과 비교하여 살균 효과를 비교 평가하였다. 열전달과 물질 혼합이 우수한 테일러 와류 혼합기에 의해 얻어진 샘플은 살균을 거치지 않은 원유 샘플의 콜로니의 면적(100%) 대비 미생물의 생존 면적이 2.03%를 나타내었으며, 임펠러(50.37%)와 마그네틱 바(29.51%)를 활용하여 살균한 샘플에 비해 더 우수한 살균 효과를 보였다.
테일러 와류 혼합기에서 10분 가열하여, 임펠러 혼합 시스템에서의 30분 가열 효과에 도달하였다. 또한 63℃ 이상에서 미생물 제거 효율이 높고 품질 저하(단백질 변성, 지질 산화)가 최소화되었음을 간접적으로 확인하였다. 연속식 가열 실험에서는 살균을 거치지 않은 원유로부터 희석된 샘플의 콜로니의 면적(100%)에 비해 테일러 와류 혼합기(37.77%)가 임펠러 혼합 방식(56.65%) 및 마그네틱 바(56.01%)에 비해 더 우월하였으며, 자외선 조사와 병행하였을 때 테일러 와류 혼합기는 34.75%로 미생물 제거 효율이 추가로 향상되었다. 배지 도말 결과, 테일러 와류 혼합기에서 유래한 콜로니는 작고 분리되어 미생물의 생장이 억제되고 있음을 확인하였다. 이러한 살균 샘플을 상온에서 보관하였을 때 산패도가 가장 낮았고, 냉장 보관을 하였을 때 젖산 생성이 최소화되어 보존성이 우수하였다. 자외선 조사는 원유의 불투명으로 인해 살균 효과가 미미하였으나, 연속식 실험에서는 유의미한 수준의 개선된 살균 효과를 확인할 수 있었다.
본 연구를 통해 테일러 와류 흐름 조건에서의 가열을 통해 미생물 제거와 품질 보존을 동시에 달성할 수 있는 식품 산업의 살균 기술을 제안할 수 있었다. 기존 혼합 방식의 낮은 살균 효율의 개선 및 원유의 품질 안전성과 저장 기간의 연장에 기여할 수 있으리라 기대된다.







